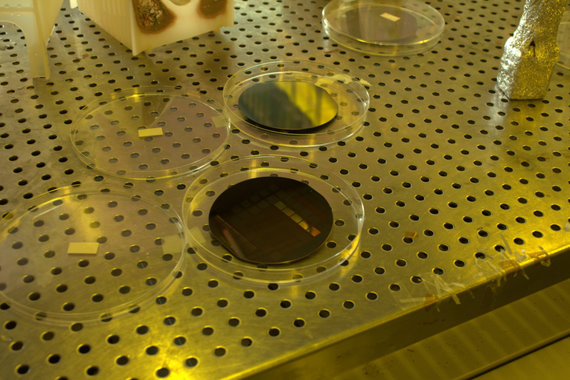

電機版圖
資電館
坐落於昆明湖畔的資電館是目前清大電機系最主要的教學基地,共有 8 層樓,並有超過 300 坪的教室空間,以及充分的硬體設施。








台達館
台達館緊鄰資電館以及清大室內游泳池,由台達電子捐款並配合清華大學「邁向頂尖大學」計畫款項建造,為地上 9 層地下 2 層的「綠色教學大樓」,樓板面積共 8,828 坪。這座通過 6 項綠建築指標的綠色建築,由電資院、奈微所以及材料系共同使用。



工三館

台積館
位於清大南校區的台積館,享由遼闊的視野以及綠草如茵的景緻,由台積電公司所捐助建造。
而電機系著名的研究機構:積體電路研究中心即座落於此。



教育館
教育館是清大校內最具有歷史意義的建築物之一,目前館內設有電子所的若干實驗室。



研發大樓
研發大樓位於清大校門口,電機系的光學實驗室以及通訊系統實驗室皆設立於此,提供同學親身操作專業儀器並學習研究技能的場所,並培養實作與動手實驗的人才。







